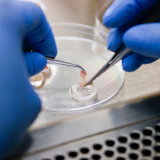
La dissection au microscope

Introduction Pourquoi est-il important d'entretenir votre microscope ? Il est crucial d'entretenir votre microscope pour garantir des résultats précis ...
Les objectifs Les objectifs sont des éléments essentiels pour votre microscope car ils déterminent la puissance de grossissement et la qualité de ...
Avantages de ce microscope Triple objectif pour des applications variées Le microscope numérique Tomlov DM602 est doté de trois objectifs (A, L et ...
Introduction L'importance de choisir le bon microscope L'importance de choisir le bon microscope ne peut être surestimée. En effet, le choix d'un ...
Présentation Le Andonstar AD407 est un microscope numérique 3D HDMI de haute qualité, conçu pour les professionnels et les amateurs de réparation de ...
Présentation Le microscope numérique portable LCD Apexel est un instrument de haute qualité qui permet d'explorer le monde microscopique avec une grande ...
Le microscope Stellar 1 de Swift est un instrument d'observation hautement performant, conçu pour les professionnels et les étudiants. Présentation Ce ...
La microscopie est un outil de recherche incroyablement puissant qui permet de visualiser des éléments invisibles à l'œil nu, comme les cellules, les ...
Les microscopes électroniques à transmission (TEM) sont des instruments de laboratoire qui permettent d'observer des échantillons à l'échelle atomique. Depuis ...
Aujourd'hui, nous allons vous parler de la fascinante et passionnante (oui, oui, on exagère un peu) étape du traitement d'images en microscopie. Vous allez ...
La coloration de Gram est une technique de laboratoire utilisée pour distinguer les bactéries en fonction de leur type de paroi cellulaire. Elle a été ...
La microscopie est une technique de visualisation qui permet d'observer des échantillons au niveau cellulaire et moléculaire. Elle est utilisée dans de ...
Le Swift SW150 est un bon microscope à bas prix qui vous permettra de vous lancer dans la microscopie amateure. Il constitue également un bon microscope de ...
Le Microscope SW350T est un microscope composé puissant et polyvalent permettant de visualiser les détails les plus infimes des lames d'échantillons ; ...
Le Swift SW380T est un microscope milieu de gamme de bonne qualité, recommandé pour une utilisation amateur en microscopie grâce à ses objectifs noirs de ...
L'un des principaux avantages du microscope est sa capacité à augmenter la résolution de l'image, permettant ainsi de voir des détails de l'objet qui ne ...
Le microcosme est un concept philosophique selon lequel l'homme est un petit univers en soi-même, en relation avec le macrocosme qui représente l'univers ...
Les termes "micro", "nano" et "pico" sont des préfixes utilisés dans les systèmes de mesure pour indiquer des multiples ou des sous-multiples d'une unité. Ces ...
Le microscope T490 est un instrument de haute précision utilisé pour observer des échantillons au niveau microscopique.
Le granite est un type de roche commun qui est formé par la cristallisation du magma en profondeur dans la croûte terrestre. Le granite est composé de ...
L'échelle nano et l'échelle micro sont deux échelles de mesure utilisées dans la microscopie et d'autres domaines de la science. L'échelle nano est l'échelle ...
Les avancées en microscopie ne cessent de repousser les limites de la science. En 2024, une découverte fascinante a émergé : des implants cérébraux ...
Salut à toi, curieux de science et passionné de microscopes ! Aujourd’hui, on va plonger dans un concept fascinant qui joue un rôle clé dans le monde de ...
Introduction : L’ère de la microscopie moléculaire La microscopie cryo-électronique (cryo-EM) a transformé notre compréhension du vivant en révélant des ...
Plongez dans le monde fascinant de la microscopie et découvrez les différents types de microscopes pour étudier les bactéries Introduction La ...
Introduction Définition d'un microscope Un microscope est un instrument optique qui permet d'observer des objets ou des échantillons trop petits pour ...
Embarquez pour une expédition passionnante au cœur du monde microscopique qui se cache dans votre propre jardin !
Le microscope à fluorescence et à champ vital : une révolution en microscopie biologique et médicale
Introduction au microscope VFF Depuis 2015, le microscope à fluorescence et à champ vital (VFF) représente une innovation et une révolution dans la ...
La microphotographie est une technique photographique qui permet de capturer des images très détaillées de sujets très petits, comme des pierres, des embryons, ...
La peau est l'organe le plus étendu du corps humain, et elle joue un rôle vital dans la protection contre les blessures, les infections et les rayonnements ...
La dissection au microscope est une technique utilisée pour examiner les organes et les tissus d'un organisme de manière précise et détaillée. Cette technique ...

Bonjour Alain, j’ai essayé de regarder dans le manuel utilisateur, sans résultat. Je n’ai pas ce modèle sous la main mais je vais me renseigner. Perso j’utilise le T490.
Avez-vous la réponse ? Cela peut intéresser d’autres personnes.
Dans tous les cas nous serions ravis si vous nous partagiez des images tirées d’un modèle neuf : contact@meilleurs-microscopes.fr
Merci et bonne observation
Auriez-vous un conseil pour un autre logiciel de traitement d’image pour faire de l’étiquetage ?
Bonjour André, que voulez-vous dire par « étiquetage » ?
Bonjour, j’en suis très satisfait!
Offert à Noël à mon fils, il est super content, les images sont incroyables, très nettes et très belles
Matriel de pro vraiment, ça me change de mes anciennes loupes qui n ont en faite rien à voir !! Je ne sais pas comment je faisais avant
Bonjour, normalement oui !
Yes merci, pour le retour Bertrand
Si vous prenez un oil condenser il se peut meme que cela ne suffise pas pour un x100 oil objective standard et vous devrez meme peut etre utiliser un objectif special avec NA variable pour GARANTIR le Dark du darkfield, j’espère avoir été clair
2. [autre question idiote] Est-ce qu’un condenseur darkfield « oil » peut être utilisé comme condenseur darkfield « dry » (auquel cas mieux vaut acquérir directement un condenseur fond noir huile puisqu’il sera polyvalent) ?
=> Il faut faire attention à l’ouverture numérique, en fait l’ouverture numérique du condenseur doit être plus grande que celle de l’objectif, le dry est le plus polyvalent mais vous « perdrez » le Dark Field pour des grossissement plus petit (~x4 en général)
Encore une fois c’est une très bonne question, et en parcourant le site je me rends compte que c’est mal expliqué (cf ouverture numérique dans Techniques de microscopie)
-Pour commencer à répondre à la question du forum pendant que je suis là, déjà c’est une très bonne question. La vérité est que si vous prenez un éclairage LED vous n’avez pas besoin du Kohler. D’ailleurs je ne sais pas pourquoi ils vendent des éclairages Halogènes + Kohler de nos jours encore, alors que l’éclairage LED est bien meilleur, même si un peu plus cher. Vous pouvez cumuler les 2 oui. Mais en pratique LED+Darkfield est la meilleure combinaison.
Bonjour, merci pour votre message, et j’ai validé votre message sur le forum encore naissant ! Je vous remercie de votre contribution. En fait le forum est déjà victime de spam et votre message était noyé dans un flux de messages… J’y répondrai dès que j’ai le temps. Le site est encore en évolution et nécessite une relecture globale, certains articles ont été rédigés par des étudiants. Donc si vous avez des questions ou des remarques elles sont les bienvenues ! Je manque d’illustrations aussi car j’avais accès à beaucoup de matos de mon labo mai je n’ai pas le droit de prendre de photos ! Etant en « transition » je n’ai pas accès à mon matos perso. Apres Noël je devrais avoir retrouvé mes affaires et mes photos sur l’ordinateur de mon labo. En attendant j’utilise des photos libres, Donc si vous avez des photos pour le site meme très simples et que vous voulez les partager n’hésitez pas! A la base le site ne devait pas être en français, il y’a je trouve du « fouillis ». Merci de vos encouragements. On essaye de rester grand public le plus possible et couvrir tous les microscopes, mais aussi de ne pas négliger les explications techniques. Pour l’instant c’est une « première couche » du projet de ce site. A bientot,
Olivier